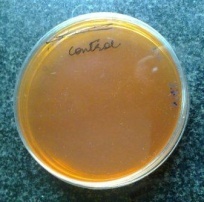
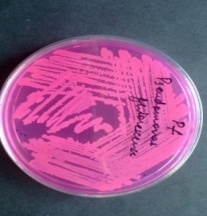

Int J Pharm Pharm Sci, Vol 7, Issue 1, 135-138Original Article
PRODUCTION, PURIFICATION AND KINETIC CHARACTERIZATION OF L-ASPARAGINASE FROM PSEUDOMONAS FLUORESCENS
RATI KUMARI SINHA1, HARE RAM SINGH1, SANTOSH KUMAR JHA1*
1Department of Bio-engineering, Birla Institute of Technology, Mesra, Ranchi 835215, Jharkhand (India).
Email: skjha@bitmesra.ac.in
Received: 16 Oct 2014 Revised and Accepted: 15 Nov 2014
ABSTRACT
Objective: L-asparaginase has been isolated from a wide variety of microbial as well as plant and animal sources. In the study the production, partial purification and kinetic characterization of L-asparaginase from Pseudomonas fluorescens were carried.
Methods: L-asparaginase was produced by submerged fermentation method. The purification of L-asparaginase was done through ammonium sulphate precipitation as well as three phase partitions (TPP) methods. Partially purified enzyme was further subjected to kinetic characterization and optimum pH and temperature determination.
Results: The purification by ammonium sulphate precipitation followed TPP produced 2.34 and 4.137 fold purified enzyme respectively. The optimum pH and temperature for the enzyme activity were found to be 7 and 37°C respectively. The Km and Vmax as determined by Lineweaver-Burk plot analysis, which was found to be 0.00451 mM and 28.57 µM/ml/min at 370C.
Conclusion: The higher activity and better kinetic properties of an enzyme in Pseudomonas fluorescens fermentation broth reflects its potential application in the field of medical and food industries.
Keywords: L-Asparaginase, Chemotherapeutic, Pseudomonas fluorescens, Lineweaver-Burk plot.
INTRODUCTION
L-Asparaginase is a naturally occurring and well known enzyme for its anti-leukemic properties. It has been effectively used in the treatment of acute lymphocytic leukemia which results from the transformation of a clone of cells from the bone marrow where early lymphoid precursors proliferate and replace the normal cells of the bone marrow [1]. L-Asparaginase (EC 3.5.1.1) deaminates L-aspartic acid and L-glutamic acid. L-Asparaginase (ASNase) inhibits protein synthesis in T-cells by catalyzing the conversion of L-asparagine to L-aspartate and ammonia and this catalytic reaction is essentially irreversible under physiological conditions [2].
Its anti-tumour properties were first revealed in guinea pig serum with a high content of L-asparaginase that caused regression of Gardener lymphosarcoma in mice. The enzyme had been found in the wide variety of sources ranging from microbial to plant and animal sources. The principle behind the use of asparaginase as an anti-tumor agent is that it takes advantage of the fact that all leukemic cells are unable to synthesize the non-essential amino acid asparagine their own, which is very essential for the growth of the tumour cells, whereas normal cells can synthesize their own asparagine. Thus malignant cells require an external source of L-asparagine for growth and multiplication. In the presence of L-asparaginase, the tumour cells get deprived of an important growth factor and cannot survive. This fact suggested the development of this enzyme as a potent anti-tumour or anti-leukemic drug [3]. Presently this enzyme is used with the brand names of ELSPAR, ONCASPAR, KIDRPLASE, ERWINASE as drug L-asparaginase has its application in food industry also. It helps in reducing the content of acrylamide in baked food products by hydrolysing the L-asparagine [4].
Although, the enzymes isolated from E. coli and Erwinia carotovora are now being used in the treatment of acute lymphoblastic leukaemia. However, due to the prolonged administration of L-asparaginase, the corresponding antibodies are produced in man, which causes an anaphylactic shock or neutralization of the drug effect. Therefore there is a continuing need to screen newer organisms in order to obtain strains capable of producing new and high yield of L-asparaginase.
In the present report, L-asparaginase enzyme was produced and purified from Pseudomonas fluorescens. Apart from ammonium sulphate precipitation method for the partial purification of L-asparaginase, Three Phase Partitioning (TPP) method was also employed as an alternative purification method for enhanced recovery of the enzyme. The principle of TPP method is mainly based on factors like salting out, co-solvent precipitation, iso-ionic precipitation etc. [5]. Various kinetic parameters like optimum pH, temperature, Km and Vmax were also identified, which gave an idea about the kinetics of L-asparaginase isolated from Pseudomonas fluorescens.
MATERIALS AND METHODS
Microorganism and culture conditions
The culture of Pseudomonas fluorescens (MTCC103) was used as the L-asparaginase producer. The isolates were sub-cultured on Luria-Bertani agar (Himedia, Mumbai, India) slants and stored at 4°C for further studies.
Preliminary screening for L-asparaginase production potential
The L-asparaginase production potential of the selected microorganism was identified by rapid plate assay method as described by Gulati et al., (1997) [6]. This method was based on the principle that L-asparaginase production leads to an increase in the pH of culture filtrates. Thus, by the use of phenol red dye as an indicator in medium containing asparagine as the sole nitrogen source, microorganisms with asparaginase producing potential can be screened by a pink zone formed around microbial colonies producing L-asparaginase. The properly autoclaved modified M9 media were used for the screening studies. The culture of Pseudomonas fluorescens was inoculated on the petriplates having the media and incubated at 37°C for 48 hours. Plates were observed for formation of pink zone around colonies.
Production of enzyme by shake flask fermentation
The batch production of enzyme was carried out in shake flask under optimized condition. The optimization was carried out by Taguchi design of experiments (DOE) method using L-18 orthogonal array. Eighteen different trial conditions were designed by QUALITEK-4 software selecting 3 different levels: maximum, minimum and intermediate level of production media containing glucose, K2HPO4, Yeast Extract, Tryptone and L-Asparagine with pH 7 to estimate the optimum condition for the better production of L-asparaginase (unpublished data).
Seed culture was prepared in 50 ml of Luria broth supplemented with 0.1 % L-Asparagine. Broth was inoculated from freshly sub-cultured Pseudomonas fluorescens from LB agar slants. The culture flask was incubated at 37°C and 180 rpm for 24 hours. The batch production of L-asparaginase was carried out by transferring 10 % (v/v) inoculum to the production media. The fermentation process was carried out at 37°C and 180 rpm agitation for a fermentation period of 48 hours.
Extraction of the crude enzyme
After the 48 hrs of post incubation, the media was transferred to several centrifuge tubes and centrifuged at 10,000 rpm for 10 min at 40C. After centrifugation, the pellet was discarded and supernatant was collected and treated as crude enzyme. This crude sample was further subjected to purification steps.
Partial purification of enzyme by ammonium sulphate precipitation
The crude enzyme was precipitated with 80% ammonium sulphate saturation according to Distasio et al. (1976) [7]. The precipitate was collected by centrifugation at 10000 rpm for 10 min and dissolved in minimal amount of 0.05M Tris-HCl buffer of pH 8.6 and then dialysed extensively against the same buffer. The temperature was maintained at 4°C throughout the experiment.
Protein purification by TPP
Precipitation of proteins was carried out by adding the ammonium sulphate upto 20-50% saturation into the fermentation broth of Pseudomonas fluorescence. It was mixed gently to dissolve the salt completely [5]. Then Iso-octane in the ratio of 0.8-1.1:1 was added and incubated at room temperature. After 1 hr of incubation, mixture was centrifuged (2000g for 10 min) at 40C to separate the mixture into three phases. The enzymatic activity was tested in interfacial precipitate and aqueous phase. Most of enzymatic activity was retained in the aqueous phase. Therefore, it was subjected to second round of TPP [8].
Estimation of enzymatic activity and amount of protein
L-asparaginase activity in the crude extract and partially purified enzyme samples was identified by the L-asparaginase (E. C.3.5.1.1) assay method of nesslerization [9]. Protein content in both crude extract and partially purified enzyme samples were estimated by the Lowry’s method of protein estimation using bovine serum albumin as standard [10].
Molecular weight determination by SDS-PAGE
SDS-PAGE was performed with a separating acrylamide gel of 12% and stacking gel of 5% containing 0.1% (w/v) SDS. The gel was stained with coomassie brilliant blue R-250 and de-stained with a solution of methanol, acetic acid and water in the ratio of 4:1:5 [11]. The purified enzyme was further concentrated by acetone and TCA to visualise the proper band during SDS PAGE.
Effect of pH on L-asparaginase activity
The effect of pH on L-asparaginase activity was studied over a pH range of 5 to 10. The enzyme assay was performed using 0.05 M Tris-HCl buffer of different pH values by nesslerization method as described above.
Effect of temperature on L-asparaginase activity
The influence of temperature on L-asparaginase activity was analysed over the temperature range of 25°C to 60°C. The enzyme assay was performed by adding 0.2 ml of purified enzyme, 0.2 ml of 0.05 M Tris-HCl buffer (pH 8.6) and 1.7 ml of L-asparagine. The reaction mix was incubated at different temperature ranging from 25°C to 60°C for about 10 min and the activity was determined as described before.
Determination of Km and Vmax
Km and Vmax of the partially purified enzyme were determined by Lineweaver-Burk plot analysis. The enzyme assay was performed with different milli-molar concentrations of L-asparagine (1-10 mM & 10-100 mM) as substrate [12].
RESULTS AND DISCUSSION
The modified M9 medium contained L-asparagine as a sole nitrogen source and phenol red as an indicator of L-asparaginase activity. L-asparagine also served as an enzyme inducer. The formation of a pink zone around the Pseudomonas fluorescens culture was an indication of the L-asparaginase production (Figure-1). Thus, the plate assay is rapid and reliable method and L-asparaginase production can be visualized directly from the plates without performing time consuming assays [13; 14].
The culture conditions for the maximum yield of enzyme were optimized by Taguchi DOE method. The L-asparaginase producing bacteria must be provided with optimum growth conditions in order to improve and increase the enzyme production without increasing the cost. It was found that the enzyme production was best in production media with Glucose, 1.5g/l; K2HPO4, 1.2g/l; Yeast Extract, 7g/l; Tryptone, 5g/l; and L-Asparagine, 0.1%; pH, 7 and at temperature 37˚C.
Purification of Pseudomonas fluorescens L-asparaginase was achieved by using 80% ammonium sulphate saturation which enhances the specific activity of the enzyme with respect to the crude enzyme i. e. from 39.9 IU/mg to 91.6 IU/mg. Purification by TPP was also performed which may be economical and easily scalable method of purification of enzymes, especially the therapeutic enzymes where 70-80% cost of the process contributed by downstream processing. The protein precipitated at the interfacial phase. The best precipitation occur with the Iso-octane to aqueous phase ratio in the range of 1:1 at 50% ammonium sulphate saturation of crude sample and its specific activity was found to be 161.9 with 4.137 fold purification as showed in Table-1. The approximate molecular weight of 160 KDa was estimated after the SDS PAGE analysis of the purified enzyme sample (Fig-2).
A gradual increase in L-asparaginase activity was observed from pH 5.0 to 7 followed by a gradual decrease of enzyme yield beyond pH 7 (Fig-3). Higher or lower than this pH (7) resulted in lower yield of L-asparaginase. Prema et al., (2013) had reported pH 8 for the optimum activity of L-asparaginase from Pseudomonas fluorescens [15]. However, in contradiction to the previous report, the present experiment showed the highest enzyme activity at pH 7. The temperature profile showed the highest L-asparaginase activity at temperature 37°C (Fig-4). Similar results were reported for L-asparaginase from Pseudomonas aeuroginosa 50071 [16], Pseudomonas stulzeri MB-405 [17], Erwinia carotovora [18]. According to Lineweaver-Burk plot analysis, Km and Vmax of L-asparaginase from Pseudomonas fluorescens was found to be 0.00451 mM and 28.57 µM/ml/min respectively (Fig-5). This indicated that the L-asparaginase enzyme from Pseudomonas fluorescens have a high affinity for its substrate L-asparagine.

(A) (B)
Fig. 1: Detection of L -asparaginase producers on plates supplemented with phenol reddye: (A) control plates; (B) plate inoculated with Pseudomonas fluorescens
Table 1: Specific activity of Crude and Purified Samples
| S. No. | Sample | Enzyme activity (IU/ml) |
Protein conc. (in mg/ml) |
Specific activity (IU/mg) |
Fold Purification |
| 1 | Crude | 27 | 0.69 | 39.130 | 1 |
| 2 | Purified (Ammonium sulphate ppt.) |
22 | 0.24 | 91.6 | 2.34 |
| 3 | Purified TPP | 34 | 0.21 | 161.9 | 4.137 |

Fig. 2: SDS-PAGE electrophoresis of partially purified L-Asparaginase enzyme (Lane 1- Molecular weight marker, Lane 2- Partially purified and concentrated sample by Acetone-TCA method, Lane 3 –crude sample)

Fig. 3: Effect of pH on L-asparaginase activity

Fig. 4: Effect of temperature on L- asparaginase activity

Fig. 5: Lineweaver-burk plot for L-asparaginase activity
CONCLUSION
In the present study Pseudomonas fluorescens had been screened for L-asparaginase producing potential and the culture conditions for the high yield of enzyme were optimized. The purification of L-asparaginase from Pseudomonas fluorescens was done by two methods; first was ammonium sulphate precipitation method which showed the specific activity of 229.16 with 2.34 fold purification which was quite higher than its crude sample with a specific activity of 92.82. The other method employed was TPP, which happened to be an economical and easily scalable method of purification of enzymes gave a specific activity of 161.9 with a purification fold of 4.137. Thus, TPP can be used as an alternative method of purification of L-asparaginase. Some of its kinetic properties were also determined. The optimum pH and temperature for the enzyme activity were found to be at pH 7 and 37°C and its affinity for the substrate was quite high as evident from its lower Km value.
CONFLICT OF INTERESTS
Declared None
ACKNOWLEDGEMENT
The authors also gratefully acknowledge Department of Bio-Engineering, Birla Institute of Technology, Mesra, Ranchi for providing infrastructure and all other facilities.
REFERENCES
- Sinha R, Singh HR, Jha SK. Microbial L-Asparaginase: present and future prospective. Int J Innov Res Sci Eng Technol 2013;2(11):7031-51.
- Jha SK, Pasrija D, Sinha RK, Singh HR, Nigam VK, Vidyarthi AS. Microbial L-Asparaginase: a review on current scenario and future prospects. Int J Pharma Sci Res 2012;3(9):3076-90.
- Savitri, Asthana N, Azmi W. Microbial L-Asparaginase. A potent anti-tumour enzyme. Indian J Biotechnol 2003;2:184-94.
- Sanches M, Krauchenco S, Polikarpov I. Structure, substrate complexation and reaction mechanism of bacterial asparaginases. Curr Chem Biol 2007;1:75-86.
- Jha SK, Pasrija D, Singh HR, Nigam VK, Vidyarthi AS. Enhanced recovery of L-asparaginase by the optimization of a three-phase partitioning system using the taguchi DOE methodology. Bioprocess J 2013;38-42.
- Gulati R, Saxena RK, Gupta R. Rapid plate assay for screening of L-asparaginase producing microorganism. Lett Appl Microbiol 1997;24:23-6.
- Distasio JA, Nrodrerman R, Kafkewitz D, Goodman D. Purification and characterization of L-Asparaginase with antilymphoma activity from Vibrio succinogenes. J Biol Chem 1976;251:6929-33.
- Biswas T, Kumari K, Singh HR, Jha SK. Optimization of three-phase partitioning system for enhanced recovery of L-asparaginase from Escherichia coli k12 using design of experiment (DOE). Int J Adv Res 2014;2(5):1142-7.
- Shirfrin S, Parrott CL, Luborsky SW. Substrate binding and intersubunit interactions in L-asparaginase. J Biol Chem 1974;249:1335-40.
- Lowry OH, Rosebrough NJ, Lewis FA, Randall RJ. Protein measurement with the folin phenol reagent. J Biol Chem 1951;93:265-75.
- Moorthy V, Ramalingam A, Sumantha A, Shankaranaya RT. Production, purification and characterisation of extracellular Lasparaginase from a soil isolate of Bacillus sp. Afr J Microbiol Res 2010;4(18):1862–7.
- Kumar NSM, Manonmani HK. Purification, characterization and kinetic propertiesof extracellular L-asparaginase produced by Cladosporium sp. World J Microbiol Biotechnol 2013;29:577-87.
- Wade HE, Robinson HK, Philips BW. Asparaginase and glutaminase activities of bacteria. J Gen Microbiol 1971;69:299-312.
- Imada A, Igasari S, Nakahama K, Isono M. Asparaginase and glutaminase activities of Microorganisms. J Gen Microbiol 1973;76:85-99.
- Prema P, Devi MN, Alagumanikumaran N. Production of Tumor Inhibitory L-asparaginase by wild and mutant strains of Pseudomonas fluorescens. Int J Ad Res 2013;1(4):163-71.
- El-Bessoumy AA, Sarhan M, Mansour J. Production, Isolation and Purification of L-Asparaginase from Pseudomonas aeruginosa 50071 using solid state fermentation. J Biochem Mol Biol 2004;37:387-93.
- Mannan S, Sinha A, Sadhukhan R, Chakrabarthy SL. Purification, characterization and antitumor activity of L-asparaginase isolated from Pseudomonas stutzeri MB-405. Curr Microbiol 1995;30:291-8.
- Maladkar NK, Singh VK, Naik SR. Fermentative production and isolation of L-asparaginase from Erwinia carotovora EC-113. Antibiot Bull 1993;35:77-86.